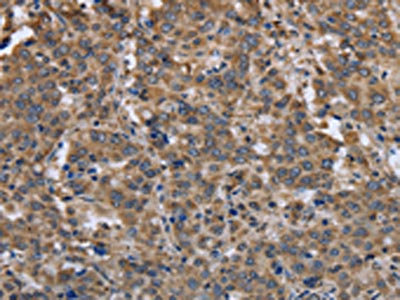

EPOR Antibody
-
中文名稱:EPOR兔多克隆抗體
-
貨號:CSB-PA914047
-
規格:¥1100
-
圖片:
-
The image on the left is immunohistochemistry of paraffin-embedded Human liver cancer tissue using CSB-PA914047(EPOR Antibody) at dilution 1/30, on the right is treated with synthetic peptide. (Original magnification: ×200)
-
The image on the left is immunohistochemistry of paraffin-embedded Human colon cancer tissue using CSB-PA914047(EPOR Antibody) at dilution 1/30, on the right is treated with synthetic peptide. (Original magnification: ×200)
-
Gel: 8%SDS-PAGE, Lysate: 40 μg, Lane: A549 cells, Primary antibody: CSB-PA914047(EPOR Antibody) at dilution 1/500, Secondary antibody: Goat anti rabbit IgG at 1/8000 dilution, Exposure time: 40 seconds
-
-
其他:
產品詳情
-
Uniprot No.:
-
基因名:
-
別名:EPOR; Erythropoietin receptor; EPO-R
-
宿主:Rabbit
-
反應種屬:Human,Mouse,Rat
-
免疫原:Synthetic peptide of Human EPOR
-
免疫原種屬:Homo sapiens (Human)
-
標記方式:Non-conjugated
-
抗體亞型:IgG
-
純化方式:Antigen affinity purification
-
濃度:It differs from different batches. Please contact us to confirm it.
-
保存緩沖液:-20°C, pH7.4 PBS, 0.05% NaN3, 40% Glycerol
-
產品提供形式:Liquid
-
應用范圍:ELISA,WB,IHC
-
推薦稀釋比:
Application Recommended Dilution ELISA 1:2000-1:5000 WB 1:500-1:2000 IHC 1:50-1:200 -
Protocols:
-
儲存條件:Upon receipt, store at -20°C or -80°C. Avoid repeated freeze.
-
貨期:Basically, we can dispatch the products out in 1-3 working days after receiving your orders. Delivery time maybe differs from different purchasing way or location, please kindly consult your local distributors for specific delivery time.
-
用途:For Research Use Only. Not for use in diagnostic or therapeutic procedures.
相關產品
靶點詳情
-
功能:Receptor for erythropoietin. Mediates erythropoietin-induced erythroblast proliferation and differentiation. Upon EPO stimulation, EPOR dimerizes triggering the JAK2/STAT5 signaling cascade. In some cell types, can also activate STAT1 and STAT3. May also activate the LYN tyrosine kinase.; Isoform EPOR-T acts as a dominant-negative receptor of EPOR-mediated signaling.
-
基因功能參考文獻:
- Here, we present two crystal structures of the human JAK2 FERM and SH2 domains bound to Leptin receptor (LEPR) and Erythropoietin receptor (EPOR), which identify a novel dimeric conformation for JAK2. PMID: 30044226
- EpoR role in the proliferation and survival of non-small cell lung cancer cells PMID: 29345289
- These results highlight the high intrinsic specificity of transmembrane domain interactions, demonstrate that a single methyl group can dictate specificity, and define the minimal chemical difference that can modulate the specificity of transmembrane domain interactions and the activity of transmembrane proteins. PMID: 28869036
- Study reports for the first evidence that EPOR modulates breast cancer cell morphology changes upon tamoxifen treatment, which result in increased formation of cell protrusions and subsequent cell death and, proposes sustained AKT phosphorylation in EPOR-overexpressing cells as a mechanism that can lead to EPOR-induced tamoxifen resistance. PMID: 28714517
- Authors retrospectively investigated whether TFR2 isoforms and EPOR are differentially expressed in MDS patients and whether the expression is associated with patients' clinical outcomes. PMID: 26914246
- High EPOR expression is associated with monoclonal gammopathy of undetermined significance and multiple myeloma. PMID: 26919105
- EPO-mediated EPOR signaling reduced the viability of myeloma cell lines and of malignant primary plasma cells in vitro PMID: 27581518
- this study shows that EPO could directly promote tumor progression via EPO receptor-expressing macrophages PMID: 27262376
- No evidence of in vivo activation of the Epo-R in WAT could be documented despite detectable levels of Epo-R mRNA. CONCLUSION: Thus, in contradiction to animal studies, Epo treatment within a physiological relevant range in humans does not exert direct effects in a subcutaneous WAT. PMID: 27640183
- Overexpression of EPOR is associated with clear cell renal cell carcinoma. PMID: 27468719
- HIF-1alpha and EPO-R may be an indicator of the aggressiveness of invasive breast cancers PMID: 27629849
- These results identify EPOR as the secondbona fidehydroxylation-dependent substrate of VHL that potentially influences oxygen homeostasis and contributes to the complex genotype-phenotype correlation in VHL disease. PMID: 26846855
- We report for a first time that functional EpoR is expressed in human rhabdomyosarcoma cell lines as well as by primary tumors from RMS patients. PMID: 26412593
- erythrocyte lineage enforces exclusivity through upregulation of EKLF and its lineage-specific cytokine receptor (EpoR) while inhibiting both FLI-1 and the receptor TpoR (also known as MPL) for the opposing megakaryocyte lineage PMID: 26159733
- A new point mutation in EPOR induces a short deletion in congenital erythrocytosis. PMID: 26010769
- Data show that erythropoietin receptor antagonist EMP9 suppressed hemoglobin synthesis in xenografts of HeLa cells. PMID: 25874769
- Data suggest that erythropoietin receptor (EPOR) could be a target to overcome therapeutic resistance toward ionizing radiation or temozolomide. PMID: 25544764
- transmembrane domain and the juxtamembrane region of the erythropoietin receptor in micelles PMID: 25418301
- while EPO can stimulate NO production, NO in turn can regulate EPOR expression in endothelial cells during hypoxia PMID: 24518819
- In HBV-related HCC, the levels of EpoR mRNA and protein in non-tumour cirrhotic livers were positively correlated with tumour cell differentiation, which is a favourable predictor of disease-specific survival. PMID: 23496059
- This study reveals high EPOR level as a potential novel positive prognostic marker in human lung lung adenocarcinoma. PMID: 24155958
- 3 novel EPOR mutations in primary familial and congenital polycythemia--Del1377-1411, a C1370A and G1445--were chimerized with EGFR to study signalling and metabolism of the chimeric receptors. PMID: 24533580
- Data show that erythropoietin receptor (EPOR) protein is expressed in breast cancer cells, where it appears to promote proliferation by an EPO-independent mechanism in estrogen receptor alpha (ERalpha) expressing breast cancer cells. PMID: 24502950
- Epo-R is expressed in bone marrow-derived macrophages from multiple myeloma and monoclonal gammopathy of undetermined significance patients. The Epo/Epo-R pathway may be involved in the regulation of angiogenic response occurring in MM. PMID: 23881169
- Data suggest that adipose tissue-specific disruption of EPO receptor does not alter adipose tissue expansion, adipocyte morphology, insulin resistance, inflammation, or angiogenesis. PMID: 23885016
- Sp1 may significantly affect the number of EPO-R molecules present on the surface of activated CD4(+) lymphocytes PMID: 23577103
- EPOR expression may be involved in tumor progression and proliferation in HER2-positive breast cancer.EPOR contributes to the mechanism of trastuzumab resistance in breast cancer. PMID: 23117856
- TAL1 binds to the EPO-R promoter to activate EPO-R expression PMID: 22982397
- High EPOR expression in OSCC is associated with an aggressive tumor behavior and poorer prognosis in the univariate analysis among patients with OSCC. PMID: 22639817
- Erythropoietin is capable of downregulating erythropoietin receptor when it acts early within HepG2 cells. PMID: 22227182
- the biology of the EpoR in ovarian cancer cells PMID: 22552716
- The absence of functional Epo receptor activity in human skeletal muscle indicates that the long-term effects are indirect and probably related to an increased oxidative capacity in this tissue PMID: 22384088
- a critical role for membrane raft in recruitment and assembly of Epo-R and signal intermediates into discrete membrane signaling units PMID: 22509308
- New knowledge concerning regulated EPOR expression and trafficking therefore is provided, together with new insight into mechanisms via which mutated EPOR-T polycythemia alleles dysregulate the erythron. PMID: 22253704
- These data support that EpoR is functional in melanoma and EpoR activation may promote melanoma progression, and suggest that Epo may stimulate angiogenesis and increase survival of melanoma cells under hypoxic condition in vivo. PMID: 21860424
- The expression of EPOR and TPOR on CD34+ CD59+ bone marrow cells are significantly higher than those on CD34+ CD59- cells of paroxysmal nocturnal hemoglobinuria patients. PMID: 22338178
- STAT5 phosphorylation levels of EPO and TPO receptors are elevated in bone marrow cells of patients with paroxysmal nocturnal hemoglobinuria. PMID: 22093990
- ETV6-RUNX1 directly activates ectopic expression of a functional EPOR and provides cell survival signals that may contribute critically to persistence of covert premalignant clones in children. PMID: 21900195
- EPOR signalling in tumour cells is involved in the control of glioma growth. PMID: 21749867
- EPO-R cytosolic lysine residues enhance receptor function, most probably through ubiquitination and/or other post-translational modifications. PMID: 21291419
- The Epo/EpoR complex plays a critical role in the adhesion and migration of rat fibroblasts, and its functional inactivation is associated with PLC-gammal-dependent reduction of cell-matrix adhesion and this also affects cell migration. PMID: 21360263
- Detected is a novel heterozygous frameshift mutation in exon 8 of the EPOR resulting in primary familial and congenital polycythaemia. PMID: 21437635
- EPOR is expressed in cells of acute leukemia, but the expression level in low. The EPOR expression rate shows no significant difference between AML and ALL. PMID: 19099624
- High EpoR is associated with angiogenesis in glioma. PMID: 20614229
- Tumor vessels exhibited EpoR, pJAK-2, and pSTAT-5 immunoreactivity PMID: 20336349
- results suggest that spermatozoa express EPO receptor on plasma membrane, which might act to protect these cells from damage after ejaculation. PMID: 20884294
- EpoR signaling is absolutely required for Parvovirus B19 replication in ex vivo-expanded erythroid progenitor cells after initial virus entry and at least partly accounts for the remarkable tropism of B19V infection for human erythroid progenitors. PMID: 20861249
- a regulatory role of EPO/EPOR pathway in human circulating endothelial precursors homeostasis PMID: 20700488
- Data show that sEpoR is detectable as a 27kDa protein in the serum of dialysis patients, and that higher serum sEpoR levels correlate with increased erythropoietin requirements. PMID: 20169072
- EpoR mRNA was detected in essentially all cell types examined, including primary endothelial, renal, cardiac, and neuronal cells but 10- to 100-fold lower than Epo-responsive cells PMID: 20124513
顯示更多
收起更多
-
相關疾病:Erythrocytosis, familial, 1 (ECYT1)
-
亞細胞定位:Cell membrane; Single-pass type I membrane protein.; [Isoform EPOR-S]: Secreted. Note=Secreted and located to the cell surface.
-
蛋白家族:Type I cytokine receptor family, Type 1 subfamily
-
組織特異性:Erythroid cells and erythroid progenitor cells. Isoform EPOR-F is the most abundant form in EPO-dependent erythroleukemia cells and in late-stage erythroid progenitors. Isoform EPOR-S and isoform EPOR-T are the predominant forms in bone marrow. Isoform EP
-
數據庫鏈接:
Most popular with customers
-
YWHAB Recombinant Monoclonal Antibody
Applications: ELISA, WB, IHC, IF, FC
Species Reactivity: Human, Mouse, Rat
-
Phospho-YAP1 (S127) Recombinant Monoclonal Antibody
Applications: ELISA, WB, IHC
Species Reactivity: Human
-
-
-
-
-
-